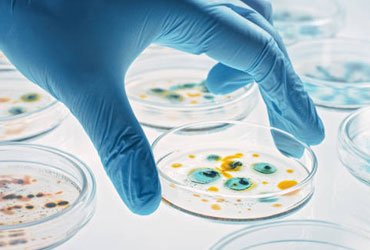

-

Welcome
to SSR BiosciencesStep for the scientific research -

Welcome
to SSR BiosciencesWhere research matters -

Welcome
to SSR BiosciencesTendency towards advanced technology -

Welcome
to SSR BiosciencesISO 9001:2015 certified
Call us
+91 9494158641
E-mail us
kiran65@ssrbiosciences.com
About SSR Biosciences LLP
SSR Biosciences is an independent research center for environmental sciences, life sciences, and applied biology, with experienced professionals. We have been in this field since 2020, providing services in a way that no one else has. Aside from that, SSR Biosciences specializes in comprehensive research and analysis of marine and coastal ecosystems. The laboratory conducts a wide range of environmental studies, with a focus on marine sampling, plankton analysis, and sediment assessment. Equipped with advanced instrumentation and staffed by experienced scientists, the laboratory collects water and sediment samples from various aquatic environments to evaluate ecosystem health and biodiversity.
OUR ACCREDITATIONS-
- Support Environmental Impact Assessments (EIA) through Marine Environmental Sampling and Compliance Monitoring Works
- We are providing water quality analysis
- We provide internship opportunities for BSc and MSc students
- We deliver the best services at the most reasonable pricing
Vision
SSR Biosciences was founded with the goal of bringing innovative technologies to industries, researchers and ambitious students. It is a cutting-edge research laboratory in Visakhapatnam designed to fulfill the requirements of students and researchers in the fields of Environmental sciences, Marine biology, Molecular Biology, Microbiology, Phytochemistry, Cytogenetics, Plant Tissue Culture, Nanobiology, and Bioinformatics.
Read MoreQuality Policy
SSR Biosciences lab facilities should be available to all science students, as the number of students in the bioscience trade is decreasing due to the scarcity of bioscience labs and their high cost. And we believe that poverty should not be an impediment to learning.
Read MoreAccreditation
SSR Biosciences, an ISO 9001:2015 certified laboratory, measures quality through the outcomes of its services. You can perceive our quality through our results, as we use cutting-edge methods and high-quality equipment to meet your needs. .
Read MoreServices we provide
You will find yourself working in a true partnership that results in an incredible
experience, and an end product that is the best.

Molecular Biology
Molecular biology investigates the molecular nature of biological processes....
Read More
Phytochemistry and pharmaceutical Biotechnology
Phytochemistry is associated with the isolation and identification of active chemical constituents of plants....
Read More
Nanobiology
Nanobiology is a new field of study that combines biological research with nanotechnologies.....
Read MoreOur Gallery








Latest Blog
title comes here one
Lorem Ipsum is simply dummy text of the printing and typesetting industry
Read More


